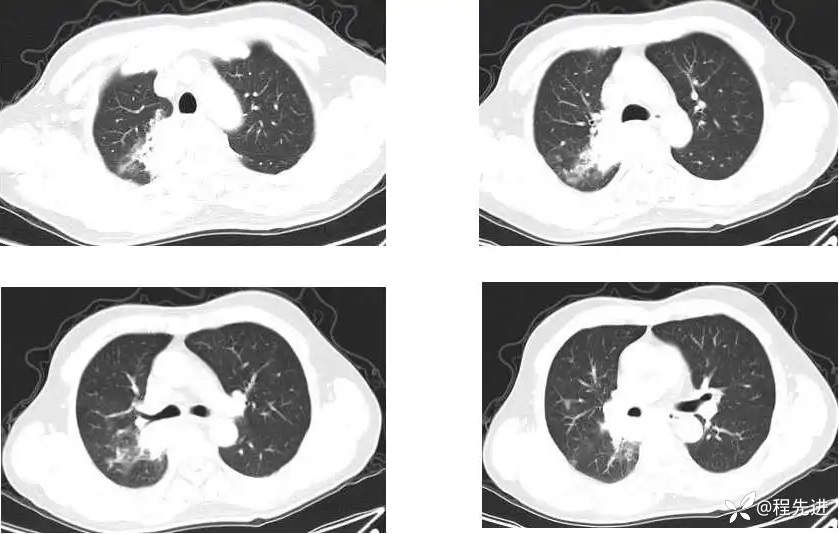
img

【心胸】特别精彩病例|间断咳嗽、痰中带血1月,发现肺门占位8天
 胡志勇HZY 等 2 位达人已点赞
胡志勇HZY 等 2 位达人已点赞病例信息
患者性别:男
患者年龄:53岁
主 诉:间断咳嗽、痰中带血1月,发现肺门占位8天
现病史:患者1月前受凉后出现咳嗽咳痰,痰中见血丝,量少,伴有右侧胸痛不适,夜间有盗汗,无发热,在社区予以抗感染治疗3天(具体用药不详),胸痛症状缓解,但仍间断出现痰中带血,未再行诊治;8天前检查发现肺门占位;患者近2日咯血量较前增多,每日约4-5口,为鲜红色
实验室检查:
血常规:白细胞:12.43↑*10^9/L;中性粒细胞计数10.43↑*10^9/L;血红蛋白:136g/L
血气分析:PH值:7.46↑
生化:天门冬氨酸氨基转移酶:13.2↓U/L,总胆固醇2.6↓mmol/L,高密度脂蛋白胆固醇:0.67↓mmol/L,低密度脂蛋白胆固醇:1.54↓mmol/L,总蛋白:56.7↓g/L,白蛋白:33.2↓g/L,钙:2.04↓mmol/LBNP、心肌标志物测定组合、肿瘤标志物6项、降钙素原检测无异常
CT增强:

MR平扫+增强:
T2压脂:

T2;

T1压脂:

T1增强;


DWI 、ADC :

期待您的点赞支持!
期待您的精彩解读!















































